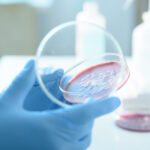

Planurile lui Laszlo Dioszegi după retrogradarea Sepsi în Liga 2
Retrogradarea Sepsi în Liga 2 a fost un șoc pentru conducerea clubului, care a reușit să păstreze câțiva jucători importanți și să întărească echipa cu altele noi, precum Joonas Tamm și Adnan Aganovic. Laszlo Dioszegi, patronul echipei, rămâne implicat în activitatea clubului, deși nu a fost foarte prezent în spațiul public.
Directorul sportiv al echipei, Attila Hadnagy, a declarat că, deși Dioszegi se ocupă de afacerile sale, își face timp pentru a se implica în echipă. „A fost un șoc foarte, foarte mare din care, încă, cred că nu ne-am revenit. Au trecut deja șase etape din Liga 2 și noi nu ne-am revenit din acest șoc. Trebuie să trecem peste și să fie o învățătură de minte. Am regândit totul, iar majoritatea jucătorilor care nu au vrut să rămână cu noi la greu au plecat. Au rămas câțiva jucători care sunt cu sufletul lângă noi. A revenit și Aganovic, iar Matei a vrut să rămână neapărat cu noi. Lângă ei, jucătorii mai tineri pot crește mai bine și, cu experiența lor, putem promova”, a spus Hadnagy.
Sepsi a obținut patru victorii consecutive în Liga 2, ajungând la 13 puncte după șapte runde, dar rămâne în afara locurilor de play-off, ocupând locul nouă. În următoarea etapă, echipa pregătită de Ovidiu Burcă va avea un test dificil, deplasându-se în Ghencea pentru a înfrunta Steaua, o altă echipă cu un start bun de sezon, dar fără drept de promovare.